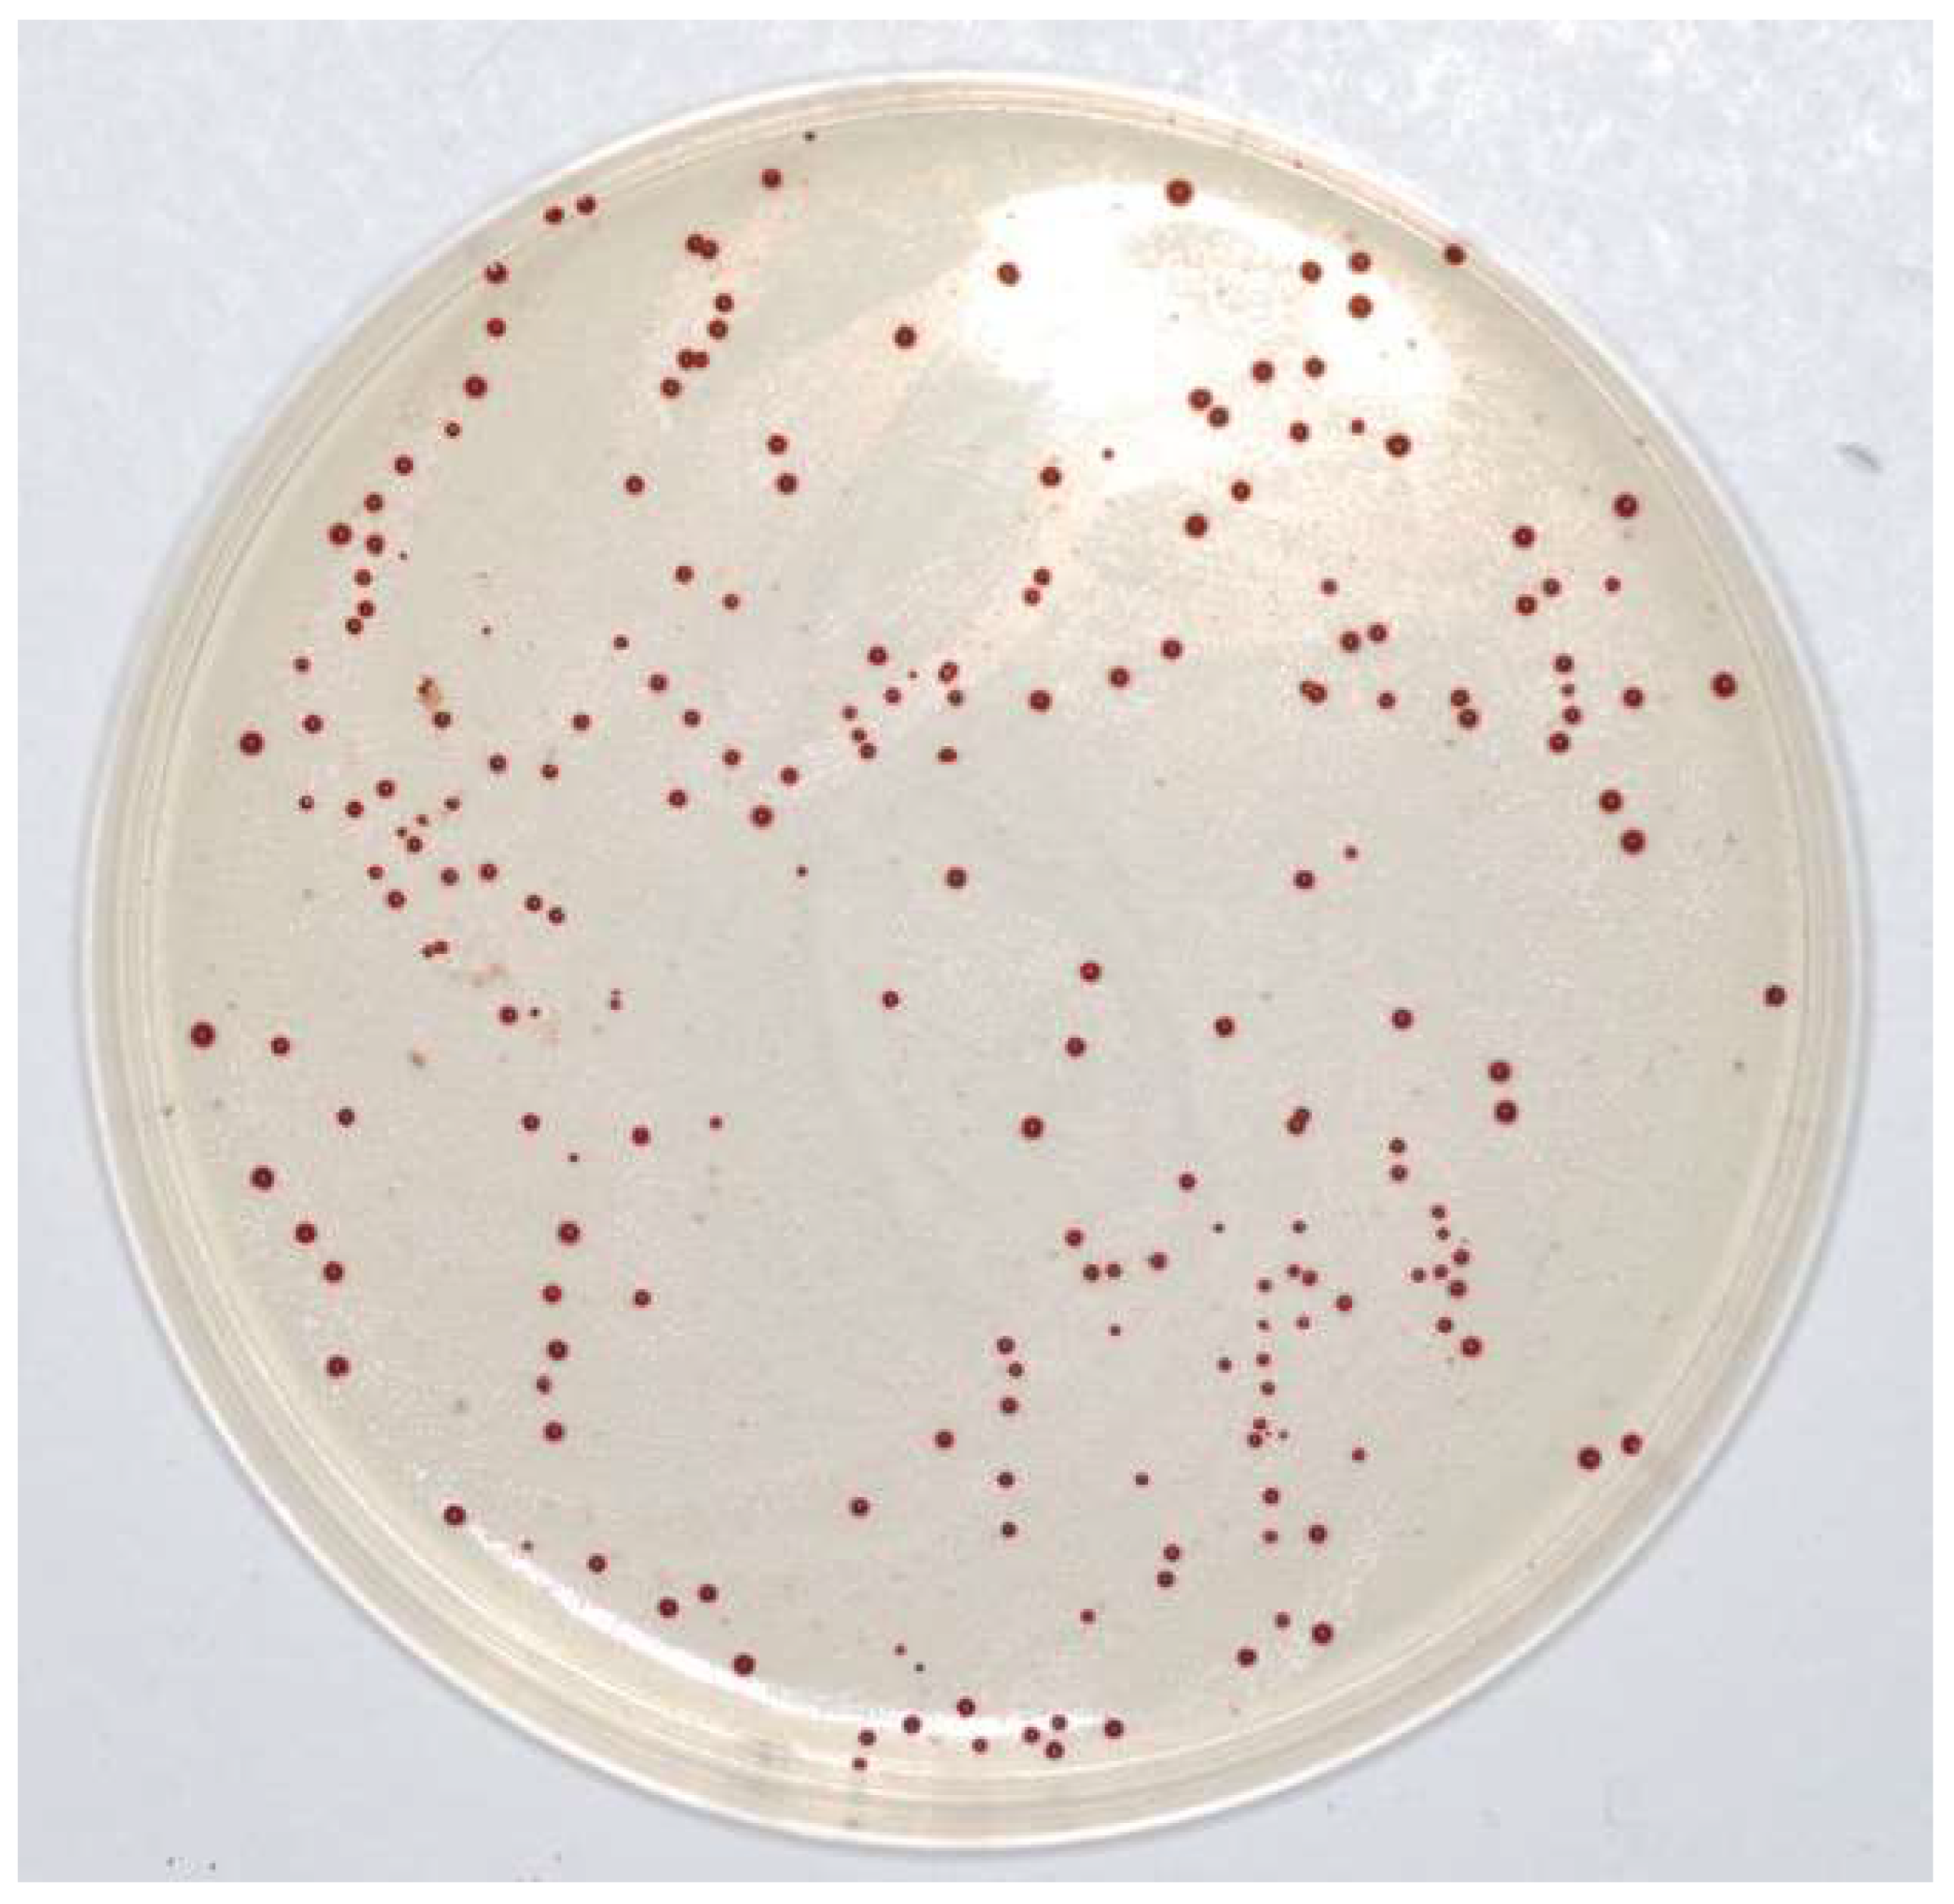
Microbiolres 13 00026 g005

Abstract
Enterococci have become major nosocomial pathogens. An increasing number of these infections are as a result of vancomycin-resistant enterococci. Accurate detection of vancomycin-resistant enterococci (VRE) is important, so that appropriate therapy and infection control measures may be instituted, including veterinary surveillance. Two screening assays to detect vancomycin resistance in enterococci are proposed. Barnes Basal Medium agar (Ba) and Brain Heart Infusion (BHI) broth (plus 1% TTC-2,3,5-triphenyltetrazolium chloride) with several concentrations of vancomycin were used in this work. Five Enterococcus casseliflavus strains with low-level resistance to vancomycin (4 µg/mL) were used. Both media were able to quickly detect the breakpoint of the vancomycin-resistant strains used in this work, and also provided insight into the dynamics of the antibiotic effect at a low concentration on the tested bacterial suspensions.
1. Introduction
The GRAS (generally recognized as safe) or the QPS (Qualified Presumption of Safety) status of Enterococcus spp. have not yet been authenticated, although enterococci, as probiotics, have been increasingly applied in human healthcare and animal husbandry, for instance as a dietary supplement, feed additive, or growth promoter. The food chain is the important route for introducing enterococci into the human gut. Enterococci have in fact been ascribed roles in food, both beneficial and detrimental [1,2,3]. In processed meats, for instance, enterococci may survive heat processing and cause spoilage, although the growth of enterococci in certain cheeses contributes to the ripening and development of product flavour [1,4]. Some enterococci of food origin produce bacteriocins that exert anti-Listeria activity [5], and some strains are used as probiotics to improve the microbial balance of the intestine, or as a treatment for gastroenteritis in humans and animals [2,3,6,7].
An impending danger, however, consists of antibiotic-resistant enterococci to the high mortality associated with infections, and to the possible spread of resistance to other bacterial species [1,3,8]. In recent years there has been an increase in nosocomial infections caused by difficult-to-treat enterococci. Enterococci are responsible for 8–12% of these types of infections, thus ranking second in the ranking of nosocomial pathogens behind Escherichia coli, and can be mentioned among those pathogens responsible for bacteraemia, endocarditis, and inflammation of the urinary tract in the health care environment [9]. Resistance is acquired by gene transfer systems, such as conjugative or non-conjugative plasmids or transposons. According to Werner et al. [8], the genomic composition of enterococci, their robust nature, their frequent occurrence in many natural habitats, and their flexibility to respond to varying environmental conditions make them a central hub (a «drug resistance gene trafficker») for resistance gene acquisition, conservation and dissemination, especially among related Gram-positive bacteria. Food also appears to be a source of vancomycin-resistant enterococci [2,8,10]. Enterococci can be used as indicators of faecal contamination, and have been implicated in outbreaks of food-borne diseases.
A major challenge for the laboratory is the rapid detection of Enterococcus spp. and the simultaneous definition of their susceptibility to antimicrobials. Usually, enterococci are isolated and identified via selective culture media, such as those that rely on the reduction of 2,3,5-triphenyltetrazolium chloride (TTC), a salt which the enterococci reduce to formazan red [11,12,13,14,15]. Since the early works of Ella M. Barnes [11,12] and L.W. Slanetz [15] back in the 1950s, the ability of enterococci of reducing 2,3,5-triphenyltetrazolium chloride to formazan red is well known and documented. Formazan dyes are artificial chromogenic products obtained by the reduction of tetrazolium salt by bacterial dehydrogenases and reductases. It is used as a redox indicator in culture media for differentiating bacteria. Slanetz and Bartley [16] used TTC m-Enterococcus agar for the enumeration of enterococci. On this medium, the colonies appear as pink to dark maroon in color. Kenner, Clark, and Kabler [13] used TTC with KF Streptococcus agar and broth to detect and enumerate streptococci in surface waters. After isolation and identification that usually require 48 h, strains are tested for antimicrobial susceptibility via the disk diffusion method or the determination of the MIC (minimum inhibitory concentration), which requires another 24 to 48 h. While in nosocomial and more specialized environments, the automation of isolation, identification, and antimicrobial susceptibility of enterococci is available, in other locations, such as food processing units or slaughterhouses there is the need for low-cost and rapid screenings.
The goal of our work was to calibrate a fast and economical method in order to simultaneously identify germs belonging to the Enterococcus spp. genus, and to determine the MIC for vancomycin. The reliability of the method was assessed by comparing the minimum inhibitory concentration obtained with the reference method of dilution on a plate. The method involved the use of 2,3,5-triphenyltetrazolium chloride (TTC), a salt which the enterococci reduce to formazan red, with different shades depending on the bacterial concentration and species [7,10,17,18].
2. Materials and Methods
2.1. Tester Strain
The tester strains used in the work were taken from the collection of the Laboratorio di Ispezione degli Alimenti di Origine Animale: E. casseliflavus, internal laboratory ref. 2091, 2093, 2903, 2904, 3005, field isolates, resistant to vancomycin using the Kirby–Bauer method [13] and carrier of the VanC gene [14]. When incubated on Brain Heart Infusion broth (BHI, Oxoid, Basingstoke, UK, CM1135) at 37 °C in air for 24 h, these strains reached approximately 1 × 109 CFU mL−1 (this is the stock suspension). Each stock suspension was serial diluted for the test in order to achieve different concentrations, as described in the Section 2.6.
2.2. Culture Media
Mueller–Hinton broth (Oxoid CM0405, hereafter, Torrance, MH, USA), Barnes agar (11853 Sigma Aldrich, Saint Louis, MO, USA, hereafter Ba) and Brain Heart Infusion Broth (Oxoid, CM1135, hereafter BHI) media were prepared for each antibiotic concentration tested. MH and BHI were sterilized in an autoclave at a temperature of 120 °C for 20′ and stored in 500-milliliter bottles. Ba was brought to a boil while stirring. Vancomycin was added to obtain the required concentrations, and then plated.
2.3. Vancomycin Stock Solution
Commencing with powdered, water-soluble vancomycin (Vancomycin HCL, Merck Life Science, Milano, Italy), an aqueous solution was prepared to obtain the required concentrations when mixing with the respective culture medium. The amount of antibiotic powder needed to obtain the required concentrations (8.0, 4.0, 2.0, 1.0, 0.9, 0.8, 0.7, 0.6, 0.5, and 0.25 µg/mL) was calculated using the following formula [19,20]:
where assay potency is provided by the manufacturer, and is usually expressed in micrograms [µg] or International Units [IU] per milligram [mg] of powder.
Weight (mg) = volume (mL)
⋅ concentration (μg/mL)
⋅ concentration (μg/mL)
assay potency (μg/mg)
2.4. Broth Microdilution Test
The broth microdilution test was performed according to CLSI guidelines. Mueller–Hinton broth was freshly prepared and used within 24h. Microplates (96 wells) containing serial dilutions of vancomycin were prepared, and each well was inoculated with test organisms in order to yield the appropriate density (105 CFU mL−1) in 100 µL of Mueller–Hinton broth (MH); plates were incubated for 24 h at 35 °C. The MIC was determined as the well with the lowest drug concentration at which there was no visible growth. A colorimetric reading on a microplate reader (Ultrospec 2100 pro, Biochrom, MA, USA) with filters at 450–490 nm and at 650 nm (for background measurement) was used.
2.5. Culture Media with Added Antibiotic and Their Inoculation
2.5.1. Barnes Agar
For Ba, surface spreading was carried out whereby the required of concentration antibiotic was added to the medium. Before inoculation, plates were left to dry at room temperature for 24 h in order to eliminate any condensation formed, then sown with 0.1 mL of bacterial suspension, distributed on the surface by means of a special hockey-stick shaped spatula, and incubated at 37 °C for 48 h before reading. Colonies of Enterococcus spp. appear red or brown with a white border.
2.5.2. Brain Heart Infusion Broth with Added TTC
Triphenyltetrazolium chloride (henceforth TTC) was added to the BHI in order to obtain a final concentration in the medium equal to 1%. Then, the antibiotic was also added to the BHI in order to obtain the required concentrations, and a volume of 4.5 mL was poured into the tubes and inoculated with 0.5 mL of bacterial suspension for each expected dilution, resulting in a final volume of 5 mL. The resulting tubes were incubated at 37 °C for 48 h before reading. The BHI broth in the positive test tube changed colour from pale yellow to pink. The Most Probable Number (MPN) was used to calculate the viable numbers of bacteria in each sample [21].
All the concentrations of antibiotic tested in the various media included a control, consisting of the medium under examination without antibiotic, and sown with the same dilutions of the bacterial suspension used to plate the media with antibiotic.
2.6. Reading of the Results
The bacterial suspension (stock suspension) was serial diluted in order to obtain the following: 108 CFU mL−1, 107 CFU mL−1, 106 CFU mL−1, 105 CFU mL−1, and 104 CFU mL−1, and plated onto Ba or inoculated into BHI. Three plates of Ba and three sets of 9 test tubes for BHI (by MPN) were used for each combination of bacterial suspension and antibiotic concentration (Figure 1 and Figure 2). Each trial was repeated three times.
Figure 1.
Sampling scheme for BHI.
Figure 2.
Sampling scheme for Barnes agar.
For each antibiotic dilution, the colonies grown in each of the consecutive Barnes agar plates were counted for each bacterial dilution. The following formula was used to determine the balanced bacterial load according to the method described by Farmiloe et al. [17]. The results were then transformed into log CFU mL−1.
where the parameters are defined as follows:
M = (∑n/V · F)/x
M = number of micro-organisms mL−1;
∑n = sum of the number of colonies grown in all plates within the range 30–300 CFU;
V = inoculated volume;
F = dilution factor;
x = number where the same digit (which corresponds to the number of plates sown for each dilution) is repeated as many times as there are plates with bacterial growth (e.g., 3 plates for each dilution, 4 dilutions: the number is 3333).
Similarly for the MPN in BHI, for each antibiotic dilution three sets of nine test tubes were used for each bacterial dilution and the average value, converted to log cfu mL−1, was recorded.
3. Results and Discussion
The results are shown in Table 1, and Figure 3 and Figure 4, and will be described by the culture media used. The results of the screening test proposed were consistent with broth microdilution tests. All of the isolates were resistant to vancomycin with MIC values of 4 µg/mL.
Table 1.
Results of the inoculum on BHI and Barnes agar, log CFU mL−1 and standard deviation (sd), n = 3.
Figure 3.
Breakpoint and evolution of the five strains of E. casseliflavus tested with the method described in this work. BHI.
Figure 4.
Breakpoint and evolution of the five strains of E. casseliflavus tested with the method described in this work. Barnes agar.
3.1. Broth Microdilution Test
The MIC for all strains was determined to be 4 µg/mL, as the wells with this concentration were the first that showed no visible growth. MIC was interpreted as the lowest concentration of drug that reduced bacterial growth by over 90% (MIC90).
3.2. BHI with 1% TTC
Table 1 and Figure 3 show that the MIC value always corresponds to 4µg mL−1, i.e., it is the lowest antibiotic concentration that fully inhibits bacterial growth for all five E. casseliflavus strains tested. The average counts for the negative control (vancomycin concentration 0 µg/mL) ranged from 8.86 (s.d. 0.06) log CFU mL−1 for Strain 2, to 8.30 (s.d. 0.00) for Strain 1, with 8.77 (0.02) for Strain 3, 8.57 (0.30) for Strain 4, and 8.85 (0.12) for Strain 5. A reduction in viable bacteria was observed immediately with the first concentration tested (0.25 µg/mL): a range of 6.24 (0.32)–8.53 (0.14) with a constant reduction in CFUs, down to values ranging from 1.00 (0.00) for Strain 5, to 3.58 for Strain 4 (0.44). No growth was observed at the breakpoint of 4 µg/mL in any test tube and the MPN was, therefore, always 0.00 (0.00). All tubes with growth had a shade ranging from pale red to bright red.
3.3. Barnes Agar
Table 1 and Figure 4 show that the MIC value always corresponds to 4µg mL−1, i.e., no growth was observed at that vancomycin concentration in any of the plates. Moreover, the reduction in CFUs for each strain was similar to that observed with BHI, with a steady decrease up to 2 µg/mL, which was the highest concentration of vancomycin, whereas the E. casseliflavus strains were still numerable in some plates: range 1.00 (0.00)–3.88 (0.56). No growth was observed at 4 µg/mL of vancomycin in any of the plates and therefore, the breakpoint was also confirmed in this case. All colonies had the typical Enterococcus spp. shape and colour, i.e., red or brown with a white border (Figure 5).
Figure 5.
Enterococus casseliflavus on Barnes agar.
Our analysis of the results enables us to state that, whereas the application of the reference method merely identifies the end point in the concentration of 4 µg mL−1, the use of the method suggested in this work enables an evaluation of the evolution of bacterial inhibition at lower concentrations to be made.
The so-called end point value for the broth microdilution test, i.e., the MIC (Minimal Inhibitory Concentration), is the minimum concentration of antibiotic that completely inhibits bacterial growth [22]. In addition to this observation, we identified not only the end point value for the proposed media, i.e., Ba and BHI, but also the evolution of the bacterial drop at increasing concentrations of vancomycin. In our opinion, in fact, it is useful to determine the MIC with the reference method in order to have an indication of the dose of antibiotic to be used in therapy. In the case of studies on the genetic drift of environmental isolates, on the other hand, it is extremely important to detect even minimal variations in the behaviour of the strains. Our approach allows even those intermediate sensitivity behaviours to antibiotics, which are often lost in epidemiological observations, to be accurately identified. As an example, let us compare the behaviour of strain 5 with strain 2, either on BHI or on Ba. At a concentration of vancomycin of 1 µg/mL in BHI, strain 5 had counts of log CFU−1 1.26 (s.d. 0.45), whereas strain 2 had 4.70 (s.d. 0.63). A similar pattern was found in Ba, with 1.00 (0.00) for strain 5, and 4.85 (0.64) for strain 2. These gradients are very important in order to assess the behaviour of enterococci during therapy or metaphylaxis. The red colour of positive BHI tubes, together with the typical aspect of colonies grown on Ba, provide not only a good presumptive diagnosis of Enterococcus spp. but also the determination of the MIC and the gradient of growth reduction.
4. Conclusions
If the purpose of the analysis is to define a therapeutic protocol, it is clear that only the application of the reference method enables concentrations of safer efficacy to be achieved. If, on the other hand, the purpose of the investigation is to obtain information on the spread of antibiotic resistance in specific communities or livestock environments, the application of the method suggested in this thesis appears more suitable.
The use of two selective, differential media for bacteria belonging to the Enterococcus genus (Barnes agar and Peptone Water with 1% TTC, both with added vancomycin) conclusively provides a further interesting indication as to the possibility of using a selective culture medium for direct isolation from food or animal samples (milk, rectal, or cloacal swabs) of vancomycin-resistant enterococci. In this case, in fact, it will be sufficient to set up a culture media with the desired antibiotic concentrations and proceed to identify the colonies that grow.
Author Contributions
Conceptualization, B.T.C.-G.; methodology, B.T.C.-G. and L.G.; formal analysis, B.T.C.-G., A.C. and L.G.; writing—original draft preparation, B.T.C.-G., M.K. and S.E.-A.; writing—review and editing, B.T.C.-G., M.K. and S.E.-A.; supervision, C.S. and J.G.-D.; project administration, B.T.C.-G.; funding acquisition, B.T.C.-G. All authors have read and agreed to the published version of the manuscript.
Funding
This research was funded by EFSA, European Food Safety Authority, grant number: EU-FORA GP/EFSA/ENCO/2018/05_ GA6.
Acknowledgments
The authors express sincere appreciation to members of Polyglot, Perugia, Italy, for a careful reading and for their comments on the manuscript.
Conflicts of Interest
The authors declare no conflict of interest.
References
- Dapkevicius, M.D.; Sgardioli, B.; Câmara, S.P.A.; Poeta, P.; Malcata, F.X. Current Trends of Enterococci in Dairy Products: A Comprehensive Review of Their Multiple Roles. Foods 2021, 10, 821. [Google Scholar] [CrossRef]
- Graham, K.; Stack, H.; Rea, R. Safety, beneficial and technological properties of enterococci for use in functional food applications—A review. Crit. Rev. Food Sci. Nutr. 2020, 60, 3836–3861. [Google Scholar] [CrossRef]
- Hanchi, H.; Mottawea, W.; Sebei, K.; Hammami, R. The Genus Enterococcus: Between Probiotic Potential and Safety Concerns—An Update. Front. Microbiol. 2018, 9, 1791. [Google Scholar] [CrossRef] [PubMed]
- Clementi, F.; Cenci-Goga, B.; Trabalza Marinucci, M.; Di Antonio, E. Use of selected starter cultures in the production of farm manufactured goat cheese from thermized milk. Ital. J. Food Sci. 1998, 10, 41–56. [Google Scholar]
- Franz, C.M.A.P.; Van Belkum, M.J.; Holzapfel, W.H.; Abriouel, H.; Gálvez, A. Diversity of enterococcal bacteriocins and their grouping in a new classification scheme. FEMS Microbiol. Rev. 2007, 31, 293–310. [Google Scholar] [CrossRef] [PubMed]
- Cenci-Goga, B.T.; Karama, M.; Sechi, P.; Iulietto, M.F.; Novelli, S.; Selvaggini, R.; Mattei, S. Growth Inhibition of Selected Microorganisms by an Association of Dairy Starter Cultures and Probiotics. Ital. J. Anim. Sci. 2015, 14, 3745. [Google Scholar] [CrossRef][Green Version]
- Grispoldi, L.; Giglietti, R.; Traina, G.; Cenci-Goga, B. How to Assess in vitro Probiotic Viability and the Correct Use of Neutralizing Agents. Front. Microbiol. 2020, 11, 204. [Google Scholar] [CrossRef] [PubMed]
- Werner, G.; Coque, T.M.; Franz, C.M.A.P.; Grohmann, E.; Hegstad, K.; Jensen, L.; van Schaik, W.; Weaver, K. Antibiotic resistant enterococci—Tales of a drug resistance gene trafficker. Int. J. Med. Microbiol. 2013, 303, 360–379. [Google Scholar] [CrossRef] [PubMed]
- European Centre for Disease Prevention Control. Surveillance of Antimicrobial Resistance in Europe 2018; ECDC Stockholm: Stockholm, Sweden, 2019. [Google Scholar]
- Cenci-Goga, B.T.; Crotti, S.; Costarelli, S.; Rondini, C.; Karama, M.; Bennett, P. Detection of tet(M) Gene from Raw Milk by Rapid DNA Extraction Followed by a Two-Step PCR with Nested Primers. J. Food Prot. 2004, 67, 2833–2838. [Google Scholar] [CrossRef] [PubMed]
- Barnes, E.M. Methods for the isolation of faecal streptococci (Lancefield group D) from bacon factories. J. Appl. Bacteriol. 1956, 19, 193–203. [Google Scholar] [CrossRef]
- Barnes, E.M. Tetrazolium Reduction as a Means of DifferentiatingA Streptococcus faecalis from Streptococcus faecium. Microbiology 1956, 14, 57–68. [Google Scholar] [CrossRef] [PubMed]
- Kenner Bernard, A.; Clark Harold, F.; Kabler Paul, W. Fecal Streptococci. Appl. Microbiol. 1961, 9, 15–20. [Google Scholar] [CrossRef] [PubMed]
- Levin, M.A.; Fischer, J.R.; Cabelli, V.J. Membrane filter technique for enumeration of enterococci in marine waters. Appl. Microbiol. 1975, 30, 66–71. [Google Scholar] [CrossRef] [PubMed]
- Slanetz, L.W.; Bent, D.F.; Bartley, C.H. Use of the membrane filter technique to enumerate enterococci in water. Public Health Rep. 1955, 70, 67–72. [Google Scholar] [CrossRef] [PubMed]
- Slanetz, L.W.; Bartley, C.H. Numbers of enterococci in water, sewage, and feces determined by the membrane filter technique with an improved medium. J. Bacteriol. 1957, 74, 591–595. [Google Scholar] [CrossRef] [PubMed]
- Cenci Goga, B.T.; Aquilanti, L.; Osimani, A.; Miraglia, D.; Aloisio, F. Identification with Multiplex PCR Assay of Enterococcus Species Isolated from Dairy Products in Umbria, Italy. Vet. Res. Commun. 2003, 27, 671–674. [Google Scholar] [CrossRef] [PubMed]
- Codega de Oliveira, A.; Bartocci, E.; Ortenzi, R.; Vizzani, A.; Cenci Goga, B.T. Detection of Enterococcus faecalis Resistant to Tetracycline by a Two-Step PCR with Nested Primers. Vet. Res. Commun. 2006, 30, 353. [Google Scholar] [CrossRef]
- CLSI. M02-A12 Performence Standards for Antimicrobial Disk Susceptibility Tests, 13th ed.; Clinical and Laboratory Standards Institute (CLSI): Wayne, PA, USA, 2018. [Google Scholar]
- CLSI. M100. Performance Standards for Antimicrobial Susceptibility Testing, 31st ed.; Clinical and Laboratory Standards Institute (CLSI): Wayne, PA, USA, 2021. [Google Scholar]
- ISO CH. ISO 4831:2006 Microbiology of Food and Animal Feeding Stuffs—Horizontal Method for the Detection and Enumeration of Coliforms—Most Probable Number Technique; ISO CH: Geneva, Switzerland, 2006. [Google Scholar]
- Mariano, V.; McCrindle, C.M.E.; Cenci-Goga, B.; Picard, J.A. Case-Control Study To Determine whether River Water Can Spread Tetracycline Resistance to Unexposed Impala (Aepyceros melampus) in Kruger National Park (South Africa). Appl. Environ. Microbiol. 2009, 75, 113. [Google Scholar] [CrossRef] [PubMed]
Publisher’s Note: MDPI stays neutral with regard to jurisdictional claims in published maps and institutional affiliations. |
© 2022 by the authors. Licensee MDPI, Basel, Switzerland. This article is an open access article distributed under the terms and conditions of the Creative Commons Attribution (CC BY) license (https://creativecommons.org/licenses/by/4.0/).